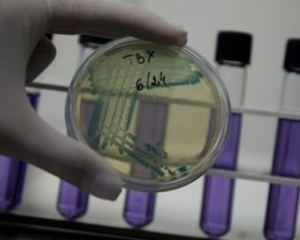

Во Франции зарегистрирована первая смерть от вспышки острой кишечной инфекции в Европе.
В субботу, 2 июля, в Бордо скончалась 78-летняя женщина, у которой была выявлены схожие симптомы заболевания.
Женщина была госпитализирована еще 24 июня с диагнозом гемолитико-уремический синдром, наиболее острая форма почечного заболевания, которую переносили пострадавшие от инфекции. Всего, по данным Всемирной организации здравоохранения, в Бордо зафиксированы восемь случаев этой болезни.
Вспышка инфекции, вызванная мутировавшей кишечной палочкой E. coli, началась в мае в Германии, где от нее умерли в общей сложности 48 человек. Еще два человека скончались в Швеции и США; перед заболеванием они посещали ФРГ.
Источник заражения долгое время найти не удавалось. Сначала причинами эпидемии назывались огурцы из Испании или ростки сои из Германии. Из-за этого многие государства запретили ввоз овощей из Европы. В итоге ВОЗ пришла к выводу, что источником заражения стали проросшие семена бобовых.
Комментарии
1